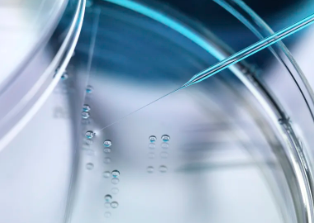
image.png

甯波幹細胞作用機制解析,真的可靠嗎?
2024-10-22 10:28:00 來源: 小編 咨詢醫生
本文将深入探讨幹細胞研究領域的最新進展,分析甯波在幹細胞作用機制研究方面的成果及其可靠性。
随着生物科學技術的不斷發展,幹細胞研究已成爲我國乃至全球科研領域的熱點。近年來,甯波在幹細胞研究領域取得了顯著成果,特别是在幹細胞作用機制方面。那麽,這些研究成果真的可靠嗎?本文将圍繞這一疑問進行解析。
首先,幹細胞是一種具有自我更新和分化潛能的細胞,它們能夠分化成各種類型的細胞,爲組織修複、疾病治療等領域提供了巨大潛力。
甯波的研究團隊在幹細胞作用機制方面的研究,主要集中在以下幾個方面:
1.幹細胞的來源和分離純化
甯波的研究團隊通過優化實驗條件,成功從多種組織中分離純化了幹細胞,并建立了相應的幹細胞庫。這爲後續的研究提供了穩定的實驗材料。
2.幹細胞分化的調控機制
甯波的研究團隊深入研究了幹細胞分化的調控機制,發現了多種關鍵因子和信号通路。這些發現有助于我們了解幹細胞分化的過程,爲臨床應用提供了理論基礎。
3.幹細胞移植治療疾病
甯波的研究團隊在幹細胞移植治療疾病方面取得了重要進展。他們發現,幹細胞移植可以改善多種疾病,如心肌梗死、神經退行性疾病等。此外,他們還揭示了幹細胞移植治療疾病的作用機制。
接下來,我們來分析一下這些研究成果的可靠性:
1.實驗方法的嚴謹性
甯波的研究團隊在實驗設計、實驗操作等方面都表現出較高的嚴謹性。他們采用了多種實驗技術,如基因敲除、基因敲入等,以确保實驗結果的可靠性。
2.數據的完整性
在研究過程中,甯波的研究團隊對實驗數據進行了詳細記錄和分析,确保了數據的完整性。這使得研究成果具有較高的可信度。
3.國際合作與交流
甯波的研究團隊與國際上的科研機構保持密切合作與交流,不斷吸取國際先進的科研理念和技術。這有助于提高研究水平和成果的可靠性。
綜上所述,甯波在幹細胞作用機制研究方面的成果具有較高的可靠性。當然,任何研究成果都需要經過時間和實踐的檢驗。在未來,我們期待甯波的科研團隊能夠在幹細胞研究領域取得更多突破,爲人類健康事業作出更大貢獻。
- 2024-11-15台州幹細胞移植醫院哪家比較好,如何進行選擇
- 2024-10-25南京鼓樓幹細胞預約流程是怎樣的?如何快速完成預約?
- 2024-11-13海南幹細胞抗衰老醫院排名揭秘,哪家治療效果好
- 2024-11-30廣州人體幹細胞哪家醫院好,評價标準是什麽
- 2024-07-23南京軍區總醫院幹細胞,南京軍區總醫院幹細胞移植怎麽樣
- 2024-11-11江西常見幹細胞檢測機構有哪些,有哪些幹細胞檢測方法
- 2024-10-10幹細胞治療肝癌靠譜嗎,有哪些成功案例分享
- 2024-09-05新冠肺炎的幹細胞治療方法有哪些
- 2024-09-28幹細胞真能改善失眠嗎,其功效如何驗證
- 2024-09-26河北幹細胞機構哪家好,2024機構名單公布
- 2024-09-11幹細胞療法臨床前景怎麽樣,未來可期
- 2024-08-19蘋果幹細胞對皮膚的功效,塗臉有用嗎
- 2024-09-05如何采集造血幹細胞,造血幹細胞采集流程詳解
- 2024-09-28航天技術如何利用幹細胞提升效果?
- 2024-09-10采集自體幹細胞的過程,自體采幹細胞的步驟
- 2024-08-22幹細胞注射面部有危險嗎,幹細胞美容的注意事項
- 2024-09-28韓城幹細胞存儲費用是如何計算的?
- 2024-09-16湖南生物幹細胞存儲公司排名榜單公布
